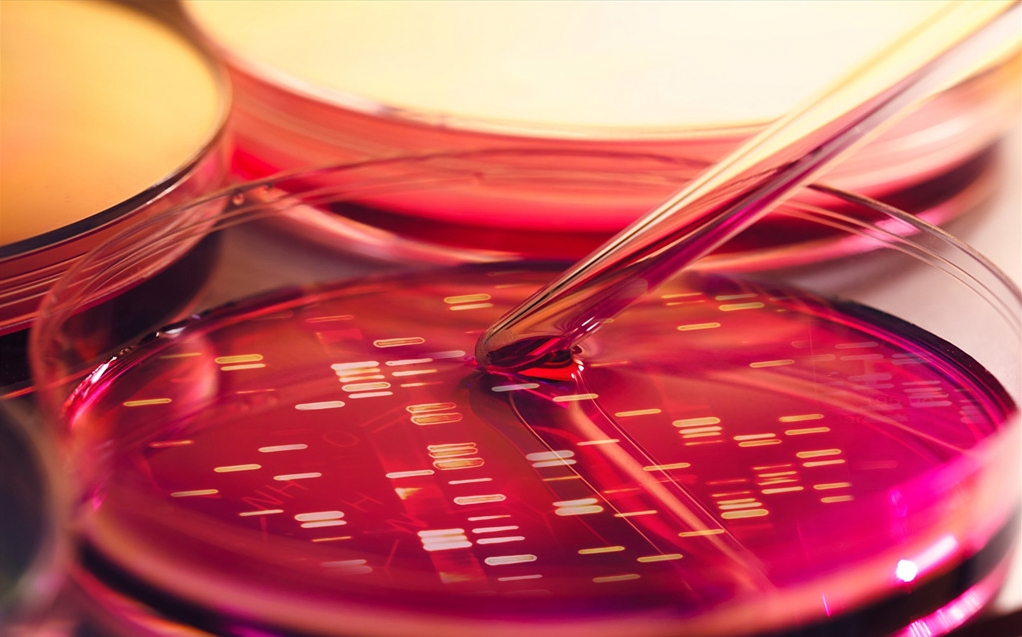

细胞简介:这株细胞取自的正常肺部组织,由J.P.Jacobs于1966年建系。正常染色体,常染色体46条概率为70%。染色体多倍概率为3.6%。冻存时为P25代。
细胞名称: MRC-5 胚肺细胞
货号: ZB019
组织来源: 肺部
细胞形态: 成纤维细胞型,且倍增次数有限
生长方式: 完全贴壁生长
培养条件: MEM+10%FBS+1%GLU+1%SP+1%NEAA+1%PS(货号:LDL-SS-C1030)
培养环境: 95%空气+5%CO2;37℃
 操作建议:
操作建议: 收到细胞后,请用 75%酒精对细胞培养瓶外表进行消毒,并将细 胞置于培养箱中稳定至少 1h 以上,待细胞形态正常,方可进行后 续操作及细胞实验。(
开封前如有污染及质疑形态请及时反馈)
1.若细胞密度未超过 85%,
且瓶上无特殊标注,则可以收集过滤多 余的培养液,视实际情况留 6-8ml 培养液培养过夜后处理。
2.细胞密度超过 75%即可以进行传代。同样收集过滤多余的培养 液,用 PBS 洗涤 1-2 次,加入 1ml 胰酶消化液,室温下消化,对 光观察,轻拍甁壁若细胞能
呈流沙状脱落,则立即用胰酶用量 2 倍以上的含 10%血清的完全培养液终止消化,可轻轻吹打几次细 胞,尽量使其变成单细胞悬液,将细胞收集于离心管中 1000r 离 心 5min 即可,弃去上清,
轻弹管底,将细胞弹散,加入 2-3ml 左右新鲜培养液重悬细胞,按所需比例进行传代。
冻存条件: 70%基础培养液+20%胎牛血清+10%DMSO(
可以使用成品冻存液)
保存条件: -80℃冰箱建议不超过 6 个月;长期保存请使用液氮 注意事项: 1. 如收到的细胞没有相关培养经验,建议第一次消化时在显微镜 下实时观察消化情况,掌握细胞的最佳消化时间,若 3 分钟内无 法脱落的细胞,可以在 37℃条件下提高胰酶活性,适当延长时间, 从加入胰酶到终止消化的过程,所有操作都要迅速;
2. 建议收到细胞后的第一次传代比例为 1/2 最多不要超过 1/3;
3. 若细胞拉丝、黏连则说明消化过度,建议适当缩短消化时间, 若发现仅有一半细胞先脱落,则可以优先终止,剩下的继续消化。售后咨询: 1.培养瓶出现破裂或漏液现象,请立即拍照并及时与我们联系;
2.开封前发现污染或质疑形态,请立即拍照并及时与我们联系;
3.发现较多细胞脱落,请先放培养箱静置 1-2h 再观察,若细胞能 够贴回,请及时传代重铺,若不能请立即拍照并与我们联系;
4.如有任何疑问,均可与我们技术人员进行反馈。

 上海致备生物科技有限公司
上海致备生物科技有限公司
Tel:021-61620296 18721120886(微信同号)
邮箱:280065473@qq.com QQ:280065473
Add.:上海市浦东新区云桥路 325 号-云创空间 220
官网www.biozb.com